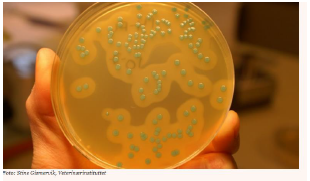

FHF søker etter nye metoder i kampen mot listeria
Listeria vokser ved lave temperaturer og har evne til å etablere seg i produksjonsmiljøer og utstyr. God produksjonshygiene og rutiner på alle nivå i en bedrift er en absolutt forutsetning for å oppnå kontroll med bakterien. Likevel ser man at dette ikke er tilstrekkelig for å sikre at laksen er fri for listeria. For å oppnå ønsket kontroll er det derfor behov for ytterligere tiltak – og FHF har nå en ny satsing der man skal få kunnskap om virkegrad og begrensninger samt kost-nytte vurderinger for anvendelse av ulike teknologier og metoder for å redusere listeria på røkt og fersk laks.
Basert på oversikten fra et tidligere avsluttet forprosjekt (901056) ble enkelte metoder valgt for videre uttesting og vurdering. Det skal nå dokumenteres hvilket potensiale metodene har til å redusere nivået av listeria på laks. Dette inkluderer blant annet faktorene som påvirker robusthet til metodene under relevante produksjonsforhold, hvordan metodene påvirker holdbarhet og spisekvalitet når de blir anvendt på laks samt kost-nytte vurderinger. Det er Nofima som er prosjektleder.
FHF satsingen vil kunne bidra til:
- Reduserte nivåer av listeria på norsk laks og lakseprodukter, noe som vil bidra til bedre omdømme, økt konkurransekraft, færre tilbakekallinger og forbedret markedsadgang for norsk laksenæring.
- At produsenter bruker ressurser på mattrygghetsstrategier med høyest kost-nytteverdi og som ikke gir uønskede konsekvenser (f.eks. endrer spisekvalitet)
- Kunnskapsgrunnlag for målretting av mattrygghetsstrategier mot bestemte produkter og prosesser for den enkelte produsent
- Økt holdbarhet, mer stabil spisekvalitet og redusert svinn
Verktøy for kontroll med listeria i laks